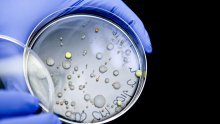
Otkriven antibiotik koji bi mogao djelovati protiv bakterija otpornih na lijekove

113 rezultata

TERAPIJA IZ BUDUĆNOSTI
Kad antibiotici prestanu djelovati: Hrvatski znanstvenik objašnjava kako nas virusi mogu spasiti od bakterija

OPASNI MIKROBI
Šokantni rezultati: Više od polovice pilećih prsa u trgovinama sadrži bakterije koje antibiotici ne mogu ubiti

prijeti ozbiljna kriza
Znanstvenici objavili zabrinjavajuće istraživanje o lijekovima koje Hrvati često koriste
nova klasa
Otkriven antibiotik koji bi mogao djelovati protiv bakterija otpornih na lijekove

preciznije doziranje
U više hrvatskih bolnica uvode se robotski sustavi za pripravu raznih lijekova

nitko ne reagira
Ovo su najsmrtonosniji patogeni u povijesti: Zašto se farmaceuti prave da ne postoje?

objavljen akcijski plan
Stručnjakinja o 'gorućem problemu': Covid je bezazlen naspram onog što dolazi

vječno pitanje
Alkohol i antibiotici: Smiju li se piti zajedno?

Nakon godina pada
U Hrvatskoj opet raste upotreba antibiotika, pogledajte brojke

opasno potkopavanje


